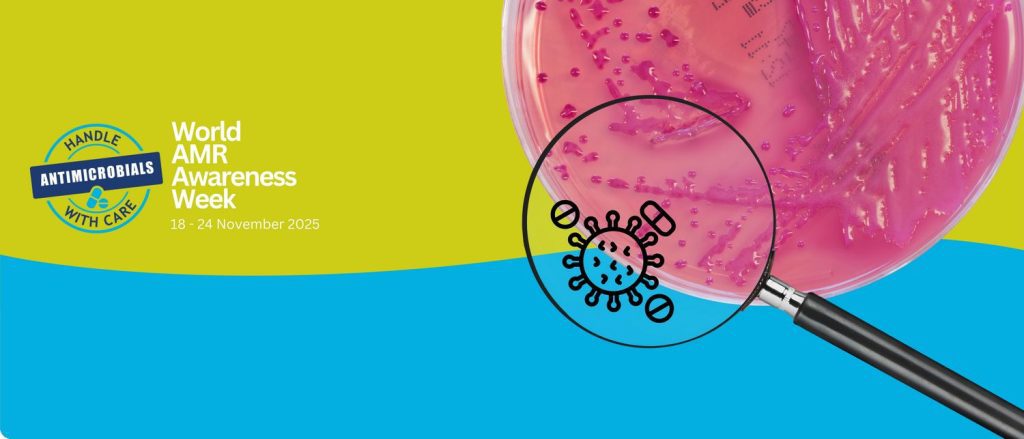
مقاومت ضدمیکروبی (AMR); هدف از پایش مقاومت ضد میکروبی و مبانی قانونی آن در اروپا

مقاومت ضدمیکروبی (AMR); هدف از پایش مقاومت ضد میکروبی و مبانی قانونی آن در اروپا
چرا پایش مقاومت ضد میکروبی (AMR) اهمیت دارد؟ مقاومت ضد میکروبی زمانی رخ میدهد که میکروبها (باکتریها، قارچها، انگلها) در برابر داروهای ضد میکروبی (آنتیبیوتیکها، آنتیفنجالها، ضد انگلها) مقاوم شوند و داروها دیگر به خوبی عمل نکنند. این پدیده خطر بزرگی برای سلامت انسان، حیوانات، تولید مواد غذایی و محیط زیست است برای مثال، در …
مقاومت ضدمیکروبی (AMR); هدف از پایش مقاومت ضد میکروبی و مبانی قانونی آن در اروپا ادامه »